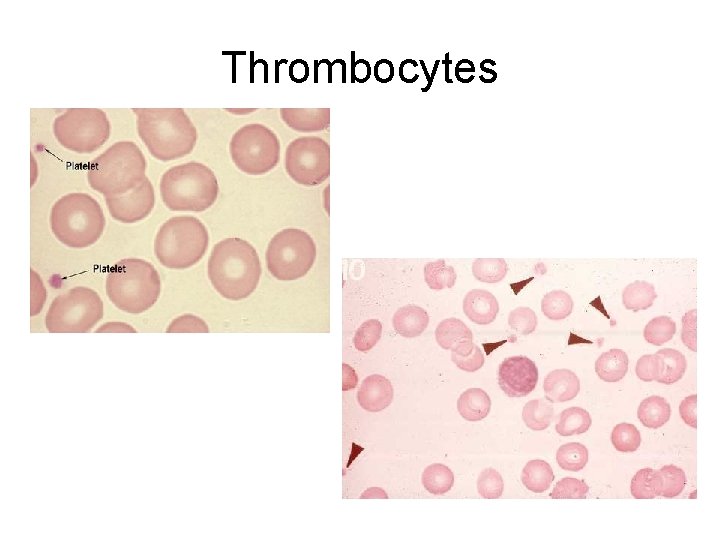

BLOOD Connective tissue with a liquid matrix Blood

BLOOD Connective tissue with a liquid matrix

Blood & blood cells • Blood volume varies with body size, changes in fluids, & amount of adipose tissue – Average adult has about 5 liters • Usually about 45% cells, 55% plasma – Most cells are red blood cells with some platelets and white blood cells – Plasma: Plasma clear liquid with a mixture of water, amino acids, proteins, carbs, lipids, vitamins, hormones, electrolytes, and cellular wastes • Hematocrit: Hematocrit volume percentage of red blood cells in a whole blood cell sample

Erythrocytes • RED blood cells (RBC’s) are biconcave disks (thinner in the middle than edges) • Hemoglobin: Hemoglobin oxygen carrying pigment that gives cells their color • After cells mature they extrude their nuclei to make more space for hemoglobin (and therefore cannot make proteins or reproduce)


Erythrocytes • Red blood cell count – Adult male: 4, 600, 000 -6, 200, 000 mm 3 – Adult female: 4, 200, 000 -5, 400, 000 mm 3 • With age, red blood cells become damaged, and are removed by macrophages in the liver and spleen (phagocytosis) • The hemoglobin is then broken down into heme (iron portion) which can be recycled and globin (protein) which forms biliverdin which can form bilirubin (bile pigments)

Erythrocyte production • Recall, blood cells form in bone (hematopoiesis) • Average RBC life span: 120 days • Hormone erythropoietin released by kidneys (and liver) controls rate of RBC formation • Respond to O 2 concentrations • B-complex vitamins significantly influence RBC production • Iron (a major component of hemoglobin) is also required for RBC production

Leukocytes • WHITE blood cells (WBC’s) protect against disease • Five types of white blood cells that differ in size, function, and cytoplasm: – Granulocytes: granular cytoplasm • Neutrophils • Eosinophils • Basophils – Agranulocytes: no cytoplasmic granules • Monocytes • Lymphocytes

Leukocytes • White blood cell count – 5000 -10, 000 cells per mm 3 • That number changes in response to abnormal conditions – A number above 10, 000 mm 3 is called leukocytosis • Indicates an acute infection (appendicitis) – A number below 5, 000 mm 3 is called leukopenia • Associated with AIDS, flu, mumps, et. al.


Leukocytes (granulocytes) • Neutrophils: Neutrophils 50 -65% of WBC’s – Phagocytize smaller particles – Contain high amounts of lysosomes • Eosinophils: Eosinophils 1 -3% of WBC’s – Help control inflammation and allergies – Remove biochemicals associated with • Basophils: Basophils less than 1% of WBC’s – Release heparin and histamine – Blood clot inhibiting substances

Leukocytes (agranulocytes) • Monocytes: Monocytes 3 -10% of WBC’s – LARGEST type of WBC – Phagocytize foreign particles • Lymphocytes: Lymphocytes 25 -35% of WBC’s – Important in immunity – Some produce antibodies

Thrombocytes • Platelets are not complete cells • Large cells called megakaryocytes fragment or shatter and produce platelets • ½ the size of a RBC • Platelet count: 130, 000 -360, 000 per mm 3 • Help to control blood loss and initiate blood clots after an injury
Thrombocytes

Blood cell formation
- Slides: 14